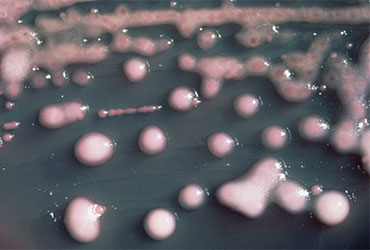

New Delhi metallo-beta-lactamase (NDM)–positive carbapenem-resistant Enterobacterales (CRE) cases have been increasing in New York City. In 2024, NDM became the most common carbapenemase, surpassing Klebsiella pneumoniae carbapenemase (KPC), which has long been the dominant carbapenemase in the United States (MMWR Morb Mortal Wkly Rep 2025;74[23]:401-403).
CRE, especially those producing carbapenemases, present a critical public health threat due to their resistance to last-line antibiotics and capacity for rapid gene transmission via plasmids.
“Historically, in the U.S. and in NYC, KPC was by far and away the most common carbapenemase among carbapenem-resistant Enterobacterales infections,” said Katelynn Devinney, MPH, a lead informatics analyst with the New York City Department of Health and Mental Hygiene. “In recent years, that epidemiology has shifted, and NYC along with other jurisdictions have been seeing a notable increase in New Delhi metallo-beta-lactamase (NDM)–positive CRE.
“What’s most concerning now is that, as of 2024 in NYC, we are actually seeing more NDM-positive CRE infections reported than KPC-positive CRE infections,” Ms. Devinney said.
A Sevenfold Increase in NDM
Between 2019 and 2024, 7,114 CRE cases were reported in NYC, 46% of which had accompanying carbapenemase test results. During this time, NYC saw a nearly sevenfold increase in NDM-positive CRE cases—from 58 to 388 annually—according to data from the NYC Department of Health and Mental Hygiene. In contrast, the incidence of KPC-positive CRE remained relatively stable, ranging from 277 to 332 cases per year.
Looking at the street addresses of individuals who were diagnosed with NDM-positive CRE, 30% of cases occurred among residents of long-term care facilities. This rate peaked at 38% during 2021 and was 25% in 2024. During the study period, age-adjusted NDM-positive CRE incidences increased annually in NYC, from less than 1 per 100,000 residents from 2018 to 2021 to 1.5 in 2022, 2.9 in 2023 and 3.8 in 2024.
What’s Causing the Increase?
While reasons for the increase are not fully understood, the increase in the proportion of NDM-positive CRE among persons without exposure to long-term care facilities suggests community transmission may be contributing to the overall rise.
“It is important for healthcare providers to be aware that NDM has become the most commonly reported carbapenemase in the NYC region, and to understand that treatment regimens for NDM-positive CRE and KPC-positive CRE are different,” Ms. Devinney said. “When data are available, it’s critical to take into account a patient’s microbiologic history along with institutional resistance data when formulating a treatment plan. However, when these data are not available, providers may want to consider empiric therapy that is effective against NDM-producing CRE—especially for patients with severe CRE infections—and should modify treatment as needed based on carbapenemase or susceptibility test results.
“Additionally, the shifting epidemiology also highlights the importance of carbapenemase testing to inform treatment decisions,” Ms. Devinney added.
Future studies will hopefully answer lingering questions regarding transmission and risk factors.
“Our surveillance data highlight the changing epidemiology of carbapenemases in NYC, but there are still unanswered questions regarding where these NDM-positive CRE infections are likely being acquired (e.g., in healthcare settings or community settings) along with what risk factors are associated with acquisition and transmission,” Ms. Devinney said.
Ms. Devinney reported no relevant financial disclosures.